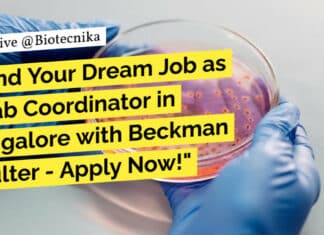
Lab Coordinator Jobs For Cell Biology, Immunology at Beckman Coulter Life Sciences "Land Your Dream Job as a Lab Coordinator in Bangalore with Beckman Coulter - Apply Now!"

JNU Genetics Project Associate Job Opening – Apply Online
JNU Genetics Project Associate Job Opening - Apply Online
School of Life Sciences
Jawaharlal Nehru University
New Delhi 110067
Applications are invited from suitable candidates for filling up...
SJRI Biology, Biotech & Biochem Job Opening, Apply Online For Mass...
SJRI Mass Spec Specialist Job Opening For Biology, Biotech & Biochem, Apply Online
Assistant Specialist, Mass Spectrometry - Analytical Project
Division: Non Division User
Project / Title:...
ILS Bhubaneswar Biotech Research Job – Apply Online
ILS Bhubaneswar Biotech Research Job - Apply Online
INSTITUTE OF LIFE SCIENCES
(An Autonomous Institute under the Dept. of Biotechnology, Ministry of Science & Technology, Govt....
Bioinformatics, Mol Bio, Immunology Job at Thermo Fisher Scientific Inc, Apply...
Bioinformatics Jobs at Thermo Fisher Scientific Inc., Apply Online
Sr. Scientist I
Location: Bangalore, Karnataka, India
Job Id: R-01223799
Job Type: Full time
Category: Research & Development
Remote: Fully Onsite
Job...
Elucidata Scientific Curator/Analyst Job For Life Sciences – Apply Now
Elucidata Scientific Curator/Analyst Job For Life Sciences - Apply Now
Scientific Curator/Analyst
Elucidata · Bengaluru, Karnataka, India
About the job
Responsibilities:
Curate and organize diverse sets of scientific...
Earn Rs. 56,000 pm at AIIMS New Delhi For Biotech, Biochem...
AIIMS Delhi Non-Med Research Job For Life Science, Biotech & Biochem
Dated: 19.02.2024
Advertisement for the post of Project Research Scientist I (Non-Medical)
Applications are invited...
Reliance Life Sciences Walk-In-Drive For MSc, MTech & BTech Biotech, Biochem...
Reliance Life Sciences Walk-In-Drive For MSc, MTech & BTech Biotech, Biochem & Microbiology
Reliance Life Sciences
WE ARE HIRING!
-Navi Mumbai-
We welcome women returning to the workforce...
Reliance Life Sciences Jobs! BSc & MSc Biotech, Biochem & Microbiology...
Reliance Life Sciences Jobs! BSc & MSc Biotech, Biochem & Microbiology Attend Walk-In
Reliance Life Sciences
WE ARE HIRING!
for Nashik and Navi Mumbai
Plasma
We welcome women returning...
MAHE Biotech Research Job – Earn Rs. 61,000 pm! Apply Now!
MAHE Biotech Research Job - Earn Rs. 61,000 pm! Apply Now!
Research Positions
Manipal Academy of Higher Education (MAHE), Manipal invites applications for the following positions...
Unbelievable Salary Alert! Earn Rs. 66,000 per Month for Life Science...
IISER Bhopal Biochemistry Job Opening - Biotech & Life Sciences Apply
Indian Institute of Science Education and Research Bhopal
Department of Biological Sciences
Bhopal By-pass...
Get Rs. 56,000 per Month as a Research Scientist at PGIMER!...
PGIMER Mol Bio Jobs - Genetics, Life Sciences Research Vacancy
Post Graduate Institute of Medical Education and Research, Chandigarh
Department of Pediatrics
Advanced Pediatrics Centre,...
Lab Coordinator Jobs For Cell Biology, Immunology at Beckman Coulter Life...
Lab Coordinator Jobs For Cell Biology, Immunology at Beckman Coulter Life Sciences
Laboratory Coordinator (Contract)
Beckman Coulter Life Sciences
Location: Bangalore, Karnataka, India
Category: Other
Job ID: R1260594
Job Description...
Clarivate Associate Pharmacovigilance Specialist For Life Science, Apply Online
Clarivate Associate Pharmacovigilance Specialist For Life Science, Apply Online
Position: Associate Pharmacovigilance Specialist
Reports To: Director, Consulting; Senior Manager, Pharmacovigilance; Manager, Pharmacovigilance
Organization: Clarivate Analytics
Position Summary:
The Associate pharmacovigilance specialist performs...
Earn Rs. 67,000 pm at NIAB – Life Sciences Apply
NIAB Project Scientist Jobs For Life Science - Apply Online
Advt. No. 07/2024
Applications are invited from suitable candidates for filling up the following position at...
High-Paying Jobs at MAHE Manipal – MSc, PhD Life Sciences Apply
Life Sciences Jobs MAHE Manipal - MSc & PhD Apply
PROJECT RESEARCH SCIENTIST - 1
Applications are invited for the position of Project Research Scientist-I (Non-Medical)...